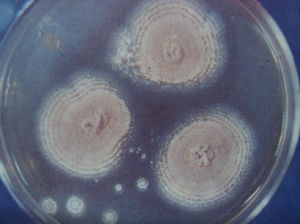
土麴黴金色變種 土麴黴金色變種

形態特徵
菌落在查氏瓊脂上25℃12天直徑40-45mm;有少量同心環或放射狀溝紋,質地絮狀,較厚,但邊緣帶絲絨狀;分生孢子結構發育遲緩,較少;菌絲體呈灰黃白色或粉紅淺黃色,近於淡赭鮭色(PaleOchraceous-Salmon,R.XV)或淺紅肉桂色(LightPinkishCinnamon,R.XXIX)到淡黃粉紅色(Buff-pink,R.XXVIII);無滲出液;無氣味;反面紅褐色或紫紅褐色,並擴散於基質。分生孢子頭呈緊密的短柱狀,達100μm×50μm;分生孢子梗發生於氣生菌絲,孢梗莖通常(80-)100-200μm×3.2-5.0μm,很少更長,多彎曲,壁平滑;頂囊球形、近球形或半球形,直徑(4.5-)8.0-14μm,約2/3乃的表面可育;產孢結構雙層;梗基5.0-7μm×2.5-3.0μm,瓶梗6.0-8.0μm×1.6-2.0μm;分生孢子球形或近球形,少橢圓形,直徑(1.6-)2.0-2.2(-2.5)μm,壁平滑。
菌落在查氏酵母膏瓊脂上25℃7天,直徑32-35mm,放射狀溝紋多,質地絮狀兼絲絨狀;中心有較多的分生孢子結構,暗黃色,近於黃褐橄欖色(Tawny-Olive,R.XXIX),其他部分很少;其他特徵和在查氏瓊脂上者很類似。
菌落在麥芽汁瓊脂上25℃12天直徑42-46mm,近邊緣具不明顯的短紋,質地絮狀,並有一些顆粒狀的菌絲團;分生孢子結構在中部較多,近於淺赭鮭色(LightOchraceousSalmon,R.XV),邊緣分生孢子結構少,淺黃白色;無滲出液;無氣味;反面紅褐色,近於煅黃土色(BurntSienna,R.II)。
生境
土壤、果皮。37℃生長。
中國分布
湖北神農架(MQ9277);雲南保山(C5944),芒市(C6556)。
世界分布
約旦、奈及利亞和尚比亞。
模式產地
美國土壤
本種特點
本變種和原變種的區別是具有明顯的絮狀菌落,分生孢子結構發育遲緩且少,營養菌絲體具黃色。
盤點麴黴屬及其相關有性型的真菌
| 麴黴屬是叢梗孢目(Moniliales)叢梗孢科中的一屬。在自然界分布極廣,是引起多種物質霉腐的主要微生物之一。本期主要是盤點該屬及其相關。 |